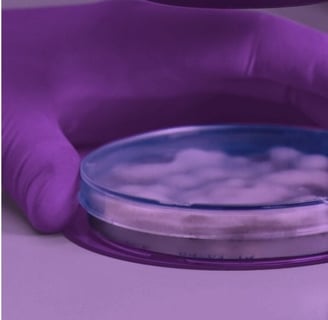

Te invita a su conferencia


MICROBIOLOGÍA Y ESTERILIZACIÓN: DE LOS FUNDAMENTOS A LA VALIDACIÓN
25 de Abril 2025
José María Velasco 101 Col. San José Insurgentes, CDMX.
Evento gratuito con cupo limitado.
8:30 - 13:30

TEMARIO Y PONENTES
Conceptos básicos.
Métodos generales de análisis.
Bioindicadores.
Diseño de patrones de carga.
Calificación de autoclaves.
Estado Validado.
Cambios en los patrones de carga.
Desviaciones e investigaciones de esterilidad.
Mantenimiento preventivo de autoclaves.
Reemplazo de tecnología.
Microbiología
Equipos de esterilización - Calificación
Sistemas de gestión de Calidad
Mantenimiento
Q.B.P. Sheila Pamela Atonal García
Egresada del IPN, con diplomado en Microbiología para la Industria Farmacéutica por ENCB-Grupo CIH México.
Cuenta con más de 10 años de experiencia en la industria farmacéutica en monitoreo de sistemas críticos (HVAC y sistema de agua), preparación de medios de cultivo, manejo de cepario, prueba de esterilidad, límites microbianos, indicadores biológicos y evaluación de sanitizantes.
Auditor líder interno y atención de auditorías por entidades regulatorias.

I.F. Juan Daniel Castillo Ávila
Egresado del IPN, con Diplomado en Habilidades gerenciales por la Universidad Anáhuac.
Con más de 15 años de trayectoria ha liderdo equipos de trabajo en Sanofi Pasteur, Merck y Laboratorios Pisa.
Especialista en validación, control de calidad y auditorías regulatorias (COFEPRIS, FDA, INVIMA).
Dirección de proyectos estratégicos CAPEX para modernización de instalaciones y tecnología.
Docente en el Instituto Politécnico Nacional y formador de talento en el sector farmacéutico.


Formulario de Registro
Recibirás un correo con tu pase de acceso.
XQV PLUS S.A. de C.V.
Horario de Servicio:
Lunes a Viernes de 8:00 a 17:00 horas.

Whats App: 55 • 1497 • 4460